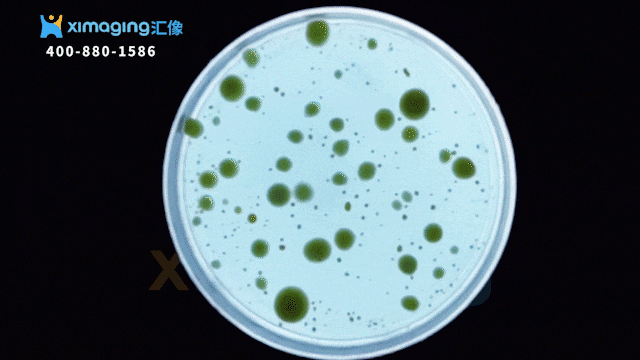

汇像科技智能微生物菌落分析大师,微生物检测的黄金搭档
微生物实验室存在大量检测平皿需要人工判读,多种检测方式并行的情况。例如在进行菌落计数实验时,检测人员需要通过肉眼或放大镜观察菌落生长状态,并对每单位检样培养的菌落进行人工判定、计数、记录。这样依赖于人工的检测实验流程复杂、操作周期长,极大的限制了微生物检验效率。重复枯燥的判读工作,让实验人员身心疲惫,实验过程中极易产生人为误差,影响检测结果的重复性。
通过人工智能与机器人技术的结合应用,汇像科技最新推出LabMasterX 实验大师系列产品——MC-2000 智能微生物菌落分析大师,机器人平台搭载菌落计数仪对平皿内菌落进行自动化计数、识别、分析,实现微生物菌落分析全流程自动化、智能化,助力打破食品微生物检验面临的长期机械操作、重复实验的困局,大幅提升检测通量,是检验工作者的黄金搭档。
LabMasterX MC-2000
智能微生物菌落分析大师
汇像科技 XImaging

汇像科技LabMasterX MC-2000智能微生物菌落分析大师以汇像自主研发的HelenX机器人和iMagicOS Lite为核心,配有1台菌落计数仪、扫码模块、微型耗材堆栈等。产品针对各种类型琼脂培养基中的菌落,通过目标菌落特征分析、计数,按照设定的规则对平皿进行初步筛选并分类处理,最后对结果进行分析、计数、审核、报告、保存并根据需要上传LIMS系统。
MC-2000可自动化处理各类型样品结果,包括倾注法、涂布法、膜过滤法、划线法等,完全符合中国药典、GB 4789系列国家标准,诸如GB4789.2-2022《食品安全国家标准 食品微生物学检验 菌落总数测定》、GB/T 5750-2023《生活饮用水标准检验方法》等,主要应用于食品、药品、化妆品、水质、疾控、医疗、检验检疫及高校科研实验室的微生物菌落检验分析和研究。
MC-2000
给忙碌的实验,一个不忙的机会
汇像科技 XImaging
▷ 自动化:重复性繁琐工作它来做
MC-2000智能微生物菌落分析大师基于微型堆栈的储存功能及机器人自动转板功能,配合菌落计数仪完成平皿的转运工作,流程全自动化,完成扫码、转移、菌落分析、初筛、结果计算等实验流程。

▷ 智能AI系统分析:避免人工误差
搭载iMagicOS Lite智能控制软件实验数据进行智能化采集、分析与反馈,避免人为误差干扰,通过计算机AI识别、记忆陌生菌落,不断优化菌落形态数据库。电子化原始记录,结合软件的审计追踪功能,确保了实验全过程可溯源性。

▷ 采用专家识别机制:提高计数准确性
独特设计的专家识别机制,针对客户样品菌落特征的特殊性,支持定制化分类导致结果偏差的点,通过AI训练识别,产生任务单由专家来进行二次识别,积累数据库资源,最终实现结果重复性与效率的双重提升,目前准确率可达95%以上。

▷ 支持结果的二次识别和人工审核
支持结果的二次识别和人工审核,图片可缩放,数据可更新。
▷ 平皿初筛:最大程度降低检验员工作量
根据成像分析结果和筛选规则,对平皿进行分类,保留需要继续鉴定复核的平皿,丢弃无用平皿(空白或者阴性),最大程度降低检验员工作量。

▷ 通量进阶 实时在线
拓展性整合自动化培养系统、移动机器人科学家,iMagicOS智慧软件实时在线监测,实现24小时高通量、无人值守的平血菌落分析实验,检验员远程读板轻松掌控实验进度。

LabMasterX
让每一位科学家化身实验艺术家
汇像科技 XImaging

汇像科技最新推出LabMasterX实验大师系列产品,以HelenX机器人和iMagicOS Lite为核心,灵活整合不同科学实验仪器,不仅能在降低生产成本的同时轻松实现实验流程的简单化、标准化、高通量、高效率,极强的数据采集和处理能力还可以实现全流程信息的可追溯与反馈,大大提升实验的准确性与客观性,真正将研究人员从繁琐重复、高强度实验操作中解放出来。
突破效率掣肘,绽放灵感光彩。LabMasterX,让每一位科学家化身实验艺术家。

---------------------------------------











